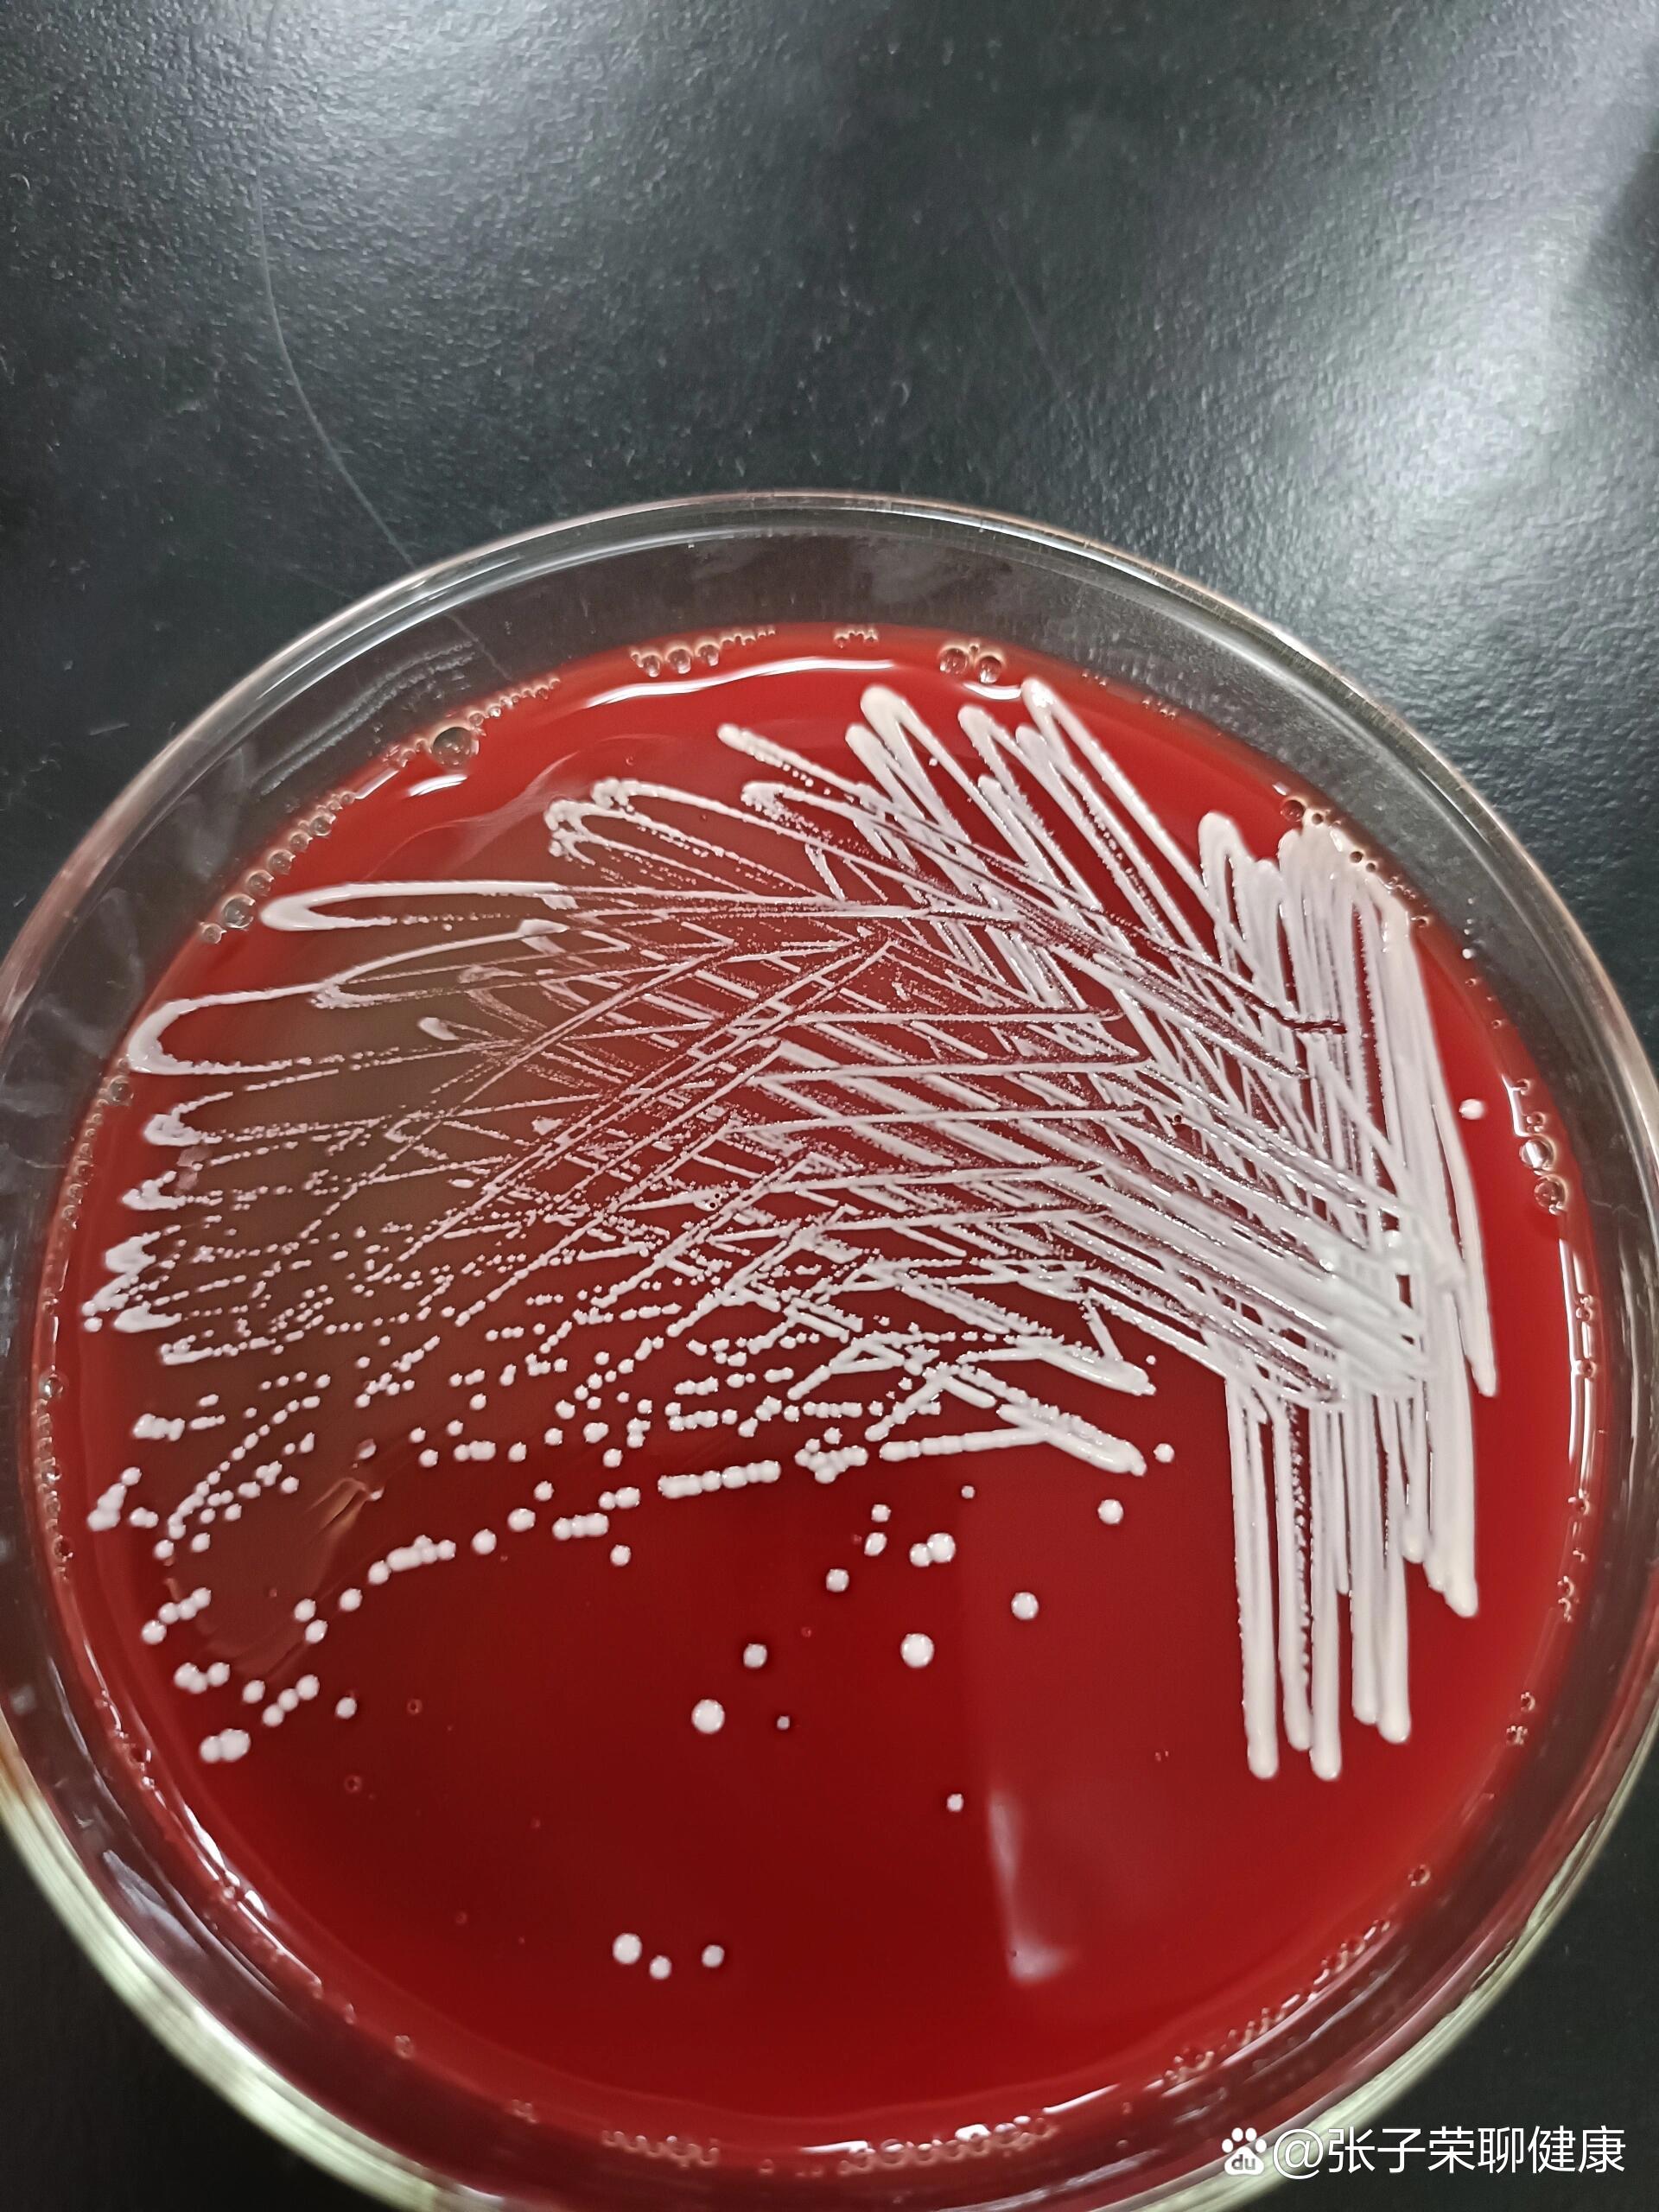
br>革兰阳性球菌,触酶阳性,of试验氧化型,新生霉素耐药,dna酶阴性.

破伤风杆菌革兰染色

不小心被扎伤一定要打破伤风针吗
图片尺寸450x337一个普通的医学生日常看细菌切片
图片尺寸1080x1047
破伤风芽孢图片
图片尺寸765x500
tetani)是一种革兰氏阳性的大杆菌,是引起破伤风的病原菌,它大量存在
图片尺寸600x449
破伤风杆菌是一种革兰氏阳性厌氧的梭状芽孢杆菌,广泛存在于土壤,灰尘
图片尺寸600x450
猪破伤风:培养物中革兰氏染色阳性球拍状的破伤风梭菌 1000 x
图片尺寸894x599
破伤风杆菌,学名"革兰氏阳性厌氧芽胞杆菌",其芽胞对外界环境的抵抗力
图片尺寸2048x1325
破伤风梭菌的生物学检查方法
图片尺寸817x570
革兰氏阳性菌 (金黄色葡萄球菌) 革兰氏阴性菌 (大肠杆菌) 常见的革兰
图片尺寸1080x810
指出下图经特殊染色法染色镜检所见的细菌特殊结构是
图片尺寸890x565
革兰阳性芽孢杆菌
图片尺寸3024x4032葡萄链球菌,大肠杆菌,水弧菌,肺炎双球菌,变形杆菌,破伤风梭菌,链球菌
图片尺寸1280x959
破伤风杆菌,属于革兰阳性厌氧芽胞杆菌.
图片尺寸488x329
破伤风梭菌剖析.ppt 38页
图片尺寸1152x864
微生物学红蓝铅笔手绘图 破伤风梭菌 产气荚膜梭菌 炭疽杆菌 肉毒梭菌
图片尺寸1280x959革兰阳性菌
图片尺寸433x582
破伤风梭状芽胞杆菌属于梭菌属,为革兰染色阳性杆菌,下方第一张图片就
图片尺寸258x178
br>革兰阳性球菌,触酶阳性,of试验氧化型,新生霉素耐药,dna酶阴性.
图片尺寸1920x2560
楼主,这就是梭状芽孢杆菌中的破伤风杆菌
图片尺寸374x410
涂片革兰染色可见较多的革兰阳性丝状分枝杆菌,弱抗酸染色为阳性(图2)
图片尺寸487x458
猜你喜欢:产气荚膜梭菌革兰染色破伤风杆菌芽孢手绘图破伤风杆菌炭疽杆菌革兰染色肉毒梭菌革兰染色破伤风杆菌芽孢染色破伤风杆菌感染破伤风杆菌菌落破伤风杆菌芽孢破伤风杆菌显微镜大肠杆菌革兰染色绘图淋球菌革兰染色破伤风杆菌图片破伤风杆菌绘图破伤风杆菌芽孢画图破伤风杆菌油镜下图片破伤风杆菌的芽孢图片革兰染色破伤风杆菌图片显微镜破伤风杆菌手绘革兰阴性杆菌革兰染色步骤肺炎链球菌革兰染色破伤风杆菌手绘图破伤风杆菌图片手绘图革兰阳性菌革兰氏阳性菌革兰染色结果绘图革兰氏阴性菌破伤风杆菌红蓝铅笔图明毅宗伊什塔尔rider简易电子琴原理图浪速号巡洋舰南京黑螯虾不忠 配图王雪涛松鹤图十年指弹吉他谱骑虎难下进退两难图片易烊千玺手绘图素描ins励志文字图片黄埔三期